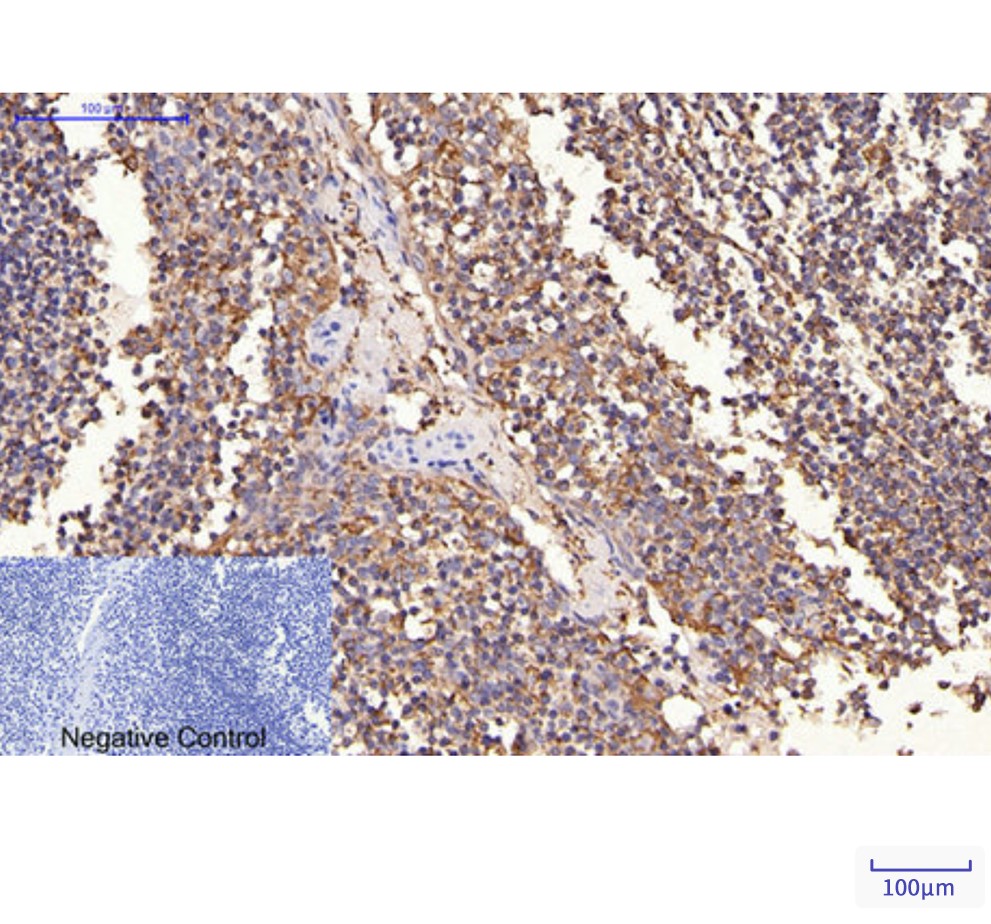

别名:ERBB2; HER2; MLN19; NEU; NGL; Receptor tyrosine-protein kinase erbB-2; Metastatic lymph node gene 19 protein; MLN 19; Proto-oncogene Neu; Proto-oncogene c-ErbB-2; Tyrosine kinase-type cell surface receptor HER2; p185erbB2; CD antigen CD340应用:WB,IHC,ICC
反应种属:Human,Mouse,Rat
规格:50μl/100μl
| Description |
|---|
| This gene encodes a member of the epidermal growth factor (EGF) receptor family of receptor tyrosine kinases. This protein has no ligand binding domain of its own and therefore cannot bind growth factors. However, it does bind tightly to other ligand-bound EGF receptor family members to form a heterodimer, stabilizing ligand binding and enhancing kinase-mediated activation of downstream signalling pathways, such as those involving mitogen-activated protein kinase and phosphatidylinositol-3 kinase. |
| Specification | |
|---|---|
| Aliases | ERBB2; HER2; MLN19; NEU; NGL; Receptor tyrosine-protein kinase erbB-2; Metastatic lymph node gene 19 protein; MLN 19; Proto-oncogene Neu; Proto-oncogene c-ErbB-2; Tyrosine kinase-type cell surface receptor HER2; p185erbB2; CD antigen CD340 |
| Entrez GeneID | 2064 |
| Swissprot | P04626 |
| clone | 1C7 |
| WB Predicted band size | Calculated MW: 138 kDa; Observed MW: 180 kDa |
| Host/Isotype | Mouse IgG1 |
| Storage | Store at 4°C short term. Aliquot and store at -20°C long term. Avoid freeze/thaw cycles. |
| Species Reactivity | Human,Mouse,Rat |
| Immunogen | Synthetic Peptide of HER2 |
| Formulation | Liquid in PBS containing 50% glycerol, 0.5% BSA and 0.02% sodium azide, pH 7.3. |
| Application | |
|---|---|
| WB | 1/500-1/1000 |
| IHC | 1/50-1/100 |
| ICC | 1/50-1/200 |
![]() |
Western blot analysis of ErbB 2 in Hela, A431, MCF-7 lysates using ErbB 2 antibody. |
![]() |
Immunohistochemistry analysis of paraffin-embedded Human Tonsil tissue using HER2 antibody.High-pressure and temperature Sodium Citrate pH 6.0 was used for antigen retrieval.Negative control was used by secondary antibody. |
本公司的所有产品仅用于科学研究或者工业应用等非医疗目的,不可用于人类或动物的临床诊断或治疗,非药用,非食用。
暂无评论
本公司的所有产品仅用于科学研究或者工业应用等非医疗目的,不可用于人类或动物的临床诊断或治疗,非药用,非食用。
中文

发表回复